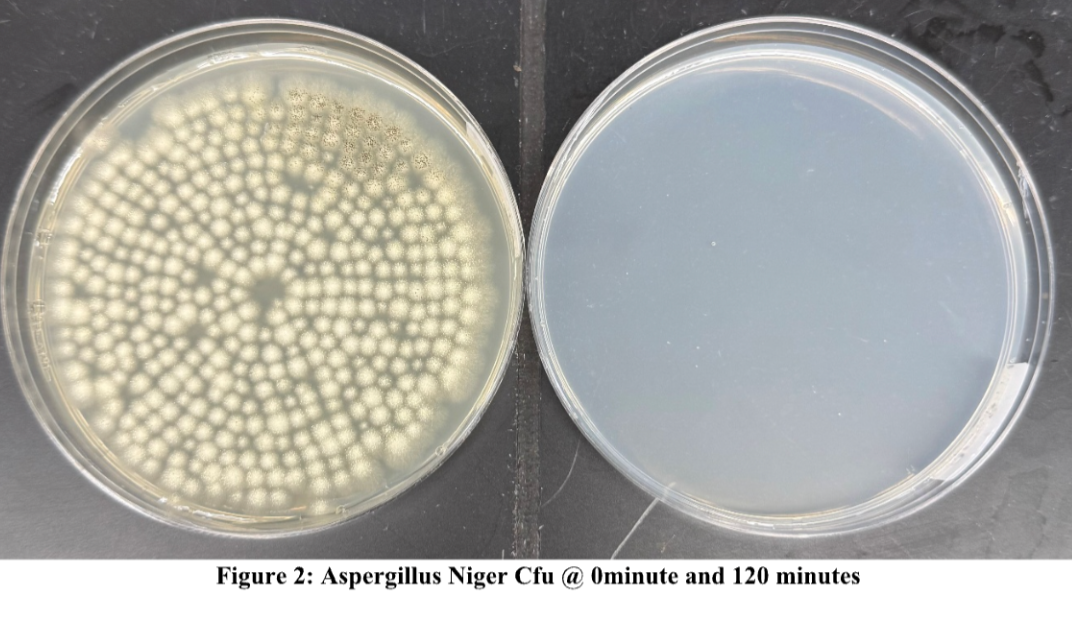

What We're Thinking About

Do I Need a Dehumidifier in My Basement? The Must-Know Reasons
Have you ever noticed a musty smell, damp walls, or even water stains in your basement? If so, you might be wondering whether you need a dehumidifier running full-time or just when problems appear. Let’s get straight to the point—yes, you need a dehumidifier in your basement permanently!
Read more
Will a Dehumidifier Help with Mold? Here’s What You Need to Know
When dealing with mold problems, you’ve likely heard that using a dehumidifier is one of the solutions. But do they really have what it takes to combat mold effectively? While dehumidifiers play an important role in preventing future mold issues by controlling moisture, they won’t eliminate existing mold or stop mold growth caused by leaks, such as roof or plumbing issues. Dehumidifiers are effective at preventing mold growth because: • They remove the primary source of mold: moisture. • They help maintain healthy humidity levels in your home. However, to fully tackle mold, you need more than just a dehumidifier. Air purifiers are essential for eliminating mold spores from the air. Let’s dive into how moisture and mold are connected, how dehumidifiers work, and why pairing them with an air purifier like Jaspr offers the most complete solution. Feature Dehumidifier Air Purifier (like Jaspr) Primary Function Reduces humidity by removing moisture Removes airborne particles (mold spores, dust, allergens) Helps Prevent Future Mold Growth? Yes, by controlling moisture levels Yes, by removing mold spores from the air Eliminates Existing Mold Spores? No Yes, captures mold spores with HEPA filters Improves Air Quality? No, focuses on humidity control Yes, improves air quality by filtering harmful particles Targets Musty Odors? No, but reduces humidity, which can help Yes, activated carbon filters remove musty odors Ideal Usage Preventing mold by reducing moisture levels Capturing and eliminating airborne mold spores and odors Connection Between Moisture and Mold Mold requires water to survive. Common sources of moisture in your home may include: • Leaky pipes • Foundation seepage • Damp areas around sinks, bathrooms, and kitchens Mold is incredibly resourceful and can thrive in high-humidity environments even without these obvious water sources. This is why managing indoor humidity levels is essential for preventing mold growth. How Dehumidifiers Help Fight Mold Dehumidifiers are a valuable tool in fighting mold because they remove excess moisture from the air, creating an environment where mold can’t thrive. While dehumidifiers won’t kill or remove mold spores already present, they do an excellent job at controlling humidity, which is critical for preventing future mold growth. How Dehumidifiers Control Humidity Levels Here’s how dehumidifiers operate to control moisture: 1. Condense Moisture from the Air: Dehumidifiers cool the air to a point where moisture condenses into water, reducing overall humidity levels. 2. Remove Condensed Moisture: The moisture is collected in a tank or drained automatically, leaving the air drier. 3. Reheat the Air: After the moisture is removed, the dehumidifier reheats the air before releasing it back into the room, ensuring the air is dry and at a comfortable temperature. A key component of most dehumidifiers is the dehumidistat, which detects moisture levels in the air. The dehumidistat activates the dehumidifier when humidity rises above the desired level, typically between 45% and 55%. This optimizes energy use by ensuring the dehumidifier runs only when necessary. The Goal of a Dehumidifier The goal of using a dehumidifier is to maintain a relative humidity level between 45% and 55%. At this level, mold, dust mites, and other allergens struggle to survive. By continuously adjusting the humidity, a dehumidifier creates an environment where mold cannot grow. However, you should avoid overusing a dehumidifier. Extremely dry air can lead to health issues like irritated sinuses and respiratory discomfort. Maintaining balanced humidity is key for both comfort and health. How to Know if Your Dehumidifier is Working Once your dehumidifier is installed, it’s important to ensure it’s working effectively to combat mold growth. Here are some signs that your dehumidifier is doing its job: • Reduced Condensation: If you notice less condensation on windows and other cool surfaces, it’s a good indication the dehumidifier is functioning properly. • Using a Hygrometer: A hygrometer allows you to monitor the humidity levels in your home accurately. Aim to keep indoor humidity between 45% and 55%. Effectiveness of Dehumidifiers in Combating Mold Dehumidifiers are highly effective at reducing moisture in the air, significantly lowering the risk of future mold growth. By consistently maintaining the right humidity levels, you can prevent mold from thriving and avoid related health risks like respiratory issues and allergy triggers. However, dehumidifiers do not kill or remove existing mold spores. Mold spores can remain dormant in the environment and become active when conditions are favorable again. This is why dehumidifiers should be used in combination with proper cleaning measures and air purifiers to fully address mold problems. Why You Need an Air Purifier Along with a Dehumidifier While dehumidifiers help prevent future mold growth, they do not remove mold spores already present in the air. This is where an air purifier like Jaspr comes into play. Equipped with HEPA filters and activated carbon filters, Jaspr effectively captures and removes mold spores and other airborne threats. Jaspr’s Role in Eliminating Mold Spores • Activated Carbon Filters: Jaspr’s carbon filters trap airborne particles, including those causing musty odors, ensuring cleaner, fresher air. • Advanced Sensors: Jaspr’s sensors continuously monitor air quality, allowing the purifier to adapt its performance in real time, tackling mold spores and dust mites before they become a problem. • HEPA Filtration: Jaspr’s HEPA filters capture tiny mold spores that are invisible to the eye but can still cause health issues. By using both a dehumidifier to control moisture and an air purifier like Jaspr to remove mold spores, you create a comprehensive defense against mold in your home. Other Ways to Prevent Mold In addition to using a dehumidifier and an air purifier, there are other steps you can take to prevent mold: • Fix leaks immediately: Address any plumbing or roof leaks as soon as they appear to prevent moisture buildup. • Improve ventilation: Make sure your home is well-ventilated, especially in high-moisture areas like bathrooms and kitchens. • Regular cleaning: Clean areas prone to moisture buildup, such as around sinks and windows, to prevent mold from gaining a foothold. Final Thoughts Dehumidifiers are essential for managing indoor humidity levels and preventing future mold growth. However, they don’t eliminate mold spores already in the air. For complete protection, combine a dehumidifier with an air purifier like Jaspr. Jaspr’s advanced filtration system removes mold spores and musty odors, ensuring a cleaner, healthier home environment. By taking these steps, you’ll protect your home from mold while improving the overall air quality for you and your family. FAQs Will a dehumidifier kill mold? No, a dehumidifier helps prevent mold by controlling humidity levels, but it won’t kill or remove mold spores already present. For that, you’ll need an air purifier like Jaspr, which captures mold spores with its HEPA and activated carbon filters. Can I use a dehumidifier and air purifier together? Yes, using a dehumidifier alongside an air purifier provides the best defense against mold. The dehumidifier reduces moisture, while the air purifier removes airborne mold spores. How often should I run my dehumidifier? It’s best to run your dehumidifier consistently, especially in humid environments like basements. Monitor the humidity levels with a hygrometer to ensure they stay between 45% and 55%. What’s the difference between a dehumidifier and an air purifier? A dehumidifier controls moisture by removing excess humidity from the air, which helps prevent mold growth. An air purifier, like Jaspr, cleans the air by removing mold spores, dust, and allergens, improving overall air quality.
Read more
99.7% of Mold Gone in 90 Minutes With Jaspr
Jaspr is excellent at reducing airborne mold. It can even reduce it to ZERO! We worked with a third party lab to conduct a study to know EXACTLY how long it would take to get the mold spores from millions of particles to none.
Read more
What Happens to Your Body When You Breathe in Cooking Grease?
Concerned about indoor air quality while cooking? Discover how airborne grease and fine particles impact your health, from respiratory irritation to long-term lung risks. Learn expert tips on reducing exposure and how Jaspr Air Purifiers can help create a cleaner, safer kitchen environment.
Read more
Do Air Purifiers Help with Dust? Yes, But Not Alone
Do Air Purifiers Help with Dust? What You Need to Know Do air purifiers help with dust? Absolutely, they do—and they are an essential part of keeping your home free from harmful particles that hitch a ride on dust. Air purifiers are particularly effective when: • Properly placed • Used with doors and windows closed • Filters are maintained regularly • Run continuously However, addressing dust requires a holistic approach that includes the correct use of your air purifier. Let’s dive into how to combat dust and how air purifiers play a critical role. Endless Dust: How Does It Affect Our Health? Dust is a relentless, unwelcome guest in our homes. It collects on bookshelves, under furniture, and even in the air we breathe. But dust is far from harmless. It’s often packed with harmful substances like: • Skin cells: These dead skin flakes become part of the dust in your home. • Pollen: Pollen infiltrates indoor spaces, especially during allergy season. • Mold spores: Found in damp conditions, mold spores travel through dust, causing respiratory issues. • Pet dander: Small flakes of skin shed by pets can add to the dust mix. • Dust mites: These microscopic creatures thrive in dusty environments and feed on dead skin cells. What’s more, household dust can carry toxic chemicals like lead, mercury, and flame retardants. Prolonged exposure to dust can lead to both mild discomfort and serious health problems, especially for people with allergies or asthma. How Dust Affects Our Health Here are a few ways dust can impact your health: • Allergies: Dust mites, pollen, and mold spores are common allergens. They trigger symptoms like sneezing, itchy eyes, and runny noses. • Asthma: Dust is a major asthma trigger, especially for children and older adults. Inhaling dust particles can irritate the airways and lead to asthma attacks. • Respiratory Infections: Dust can harbor bacteria, viruses, and other pathogens, increasing the risk of bronchitis or pneumonia. • Skin Irritation: Dust mites and other particles can aggravate skin conditions like eczema or dermatitis, especially in people with sensitive skin. It’s clear that dust isn’t just an inconvenience—it can have serious implications for your health. This makes air purification an essential strategy for maintaining a cleaner, healthier home. How to Get Dust Out of the Air While it’s impossible to completely eliminate dust, there are strategies you can use to significantly reduce it. Here’s how you can improve your indoor air quality: Regular Cleaning and Dusting Routine cleaning is one of the most effective ways to combat dust buildup. Focus on cleaning floors, furniture, and vents regularly to reduce dust accumulation. Decluttering can also help, as fewer surfaces mean less space for dust to settle. Proper Ventilation Ventilation is crucial for reducing dust and improving indoor air quality. Opening windows, using exhaust fans, and installing air exchange systems can help—but keep in mind that outside air may bring in more dust during certain seasons. Air Purifiers Air purifiers are an incredibly effective tool for removing dust from the air. Those equipped with HEPA filters can capture even the smallest dust particles, ensuring cleaner, healthier air. How Do Air Purifiers Help with Dust? Air purifiers use filters and fans to pull in air, trap dust particles, and release clean air back into the room. Here’s how they do it: 1. Air is drawn into the purifier. 2. The air passes through multiple filters: Pre-filters capture larger particles like hair and lint, while HEPA filters trap smaller particles like dust, pollen, and pet dander. 3. Clean air is released back into your space. For example, Jaspr air purifiers come equipped with advanced filtration, including pre-filters and HEPA filters, which are highly effective at capturing dust particles, ensuring the air you breathe is much cleaner. Tackling Harmful Hitchhikers: Dust and Other Pollutants Dust doesn’t just accumulate; it serves as a vehicle for other harmful particles like mold spores, pollen, and toxic chemicals. This makes air purification even more important. A high-quality purifier not only captures dust but also reduces these hitchhiking pollutants, protecting you from their adverse health effects. How to Maximize Your Air Purifier’s Effectiveness To get the most out of your air purifier, follow these steps: • Choose the right placement: Place the purifier in the room where dust tends to accumulate the most, ensuring it’s free from obstructions. • Keep doors and windows closed: This helps your purifier focus on cleaning the air in a specific space without pulling in more dust from outside. • Clean and replace filters regularly: A clogged filter won’t work as efficiently. Follow the manufacturer’s guidelines for replacing filters—typically every 6 to 12 months. • Run the air purifier continuously: For ongoing dust control, it’s best to keep your air purifier running throughout the day. Final Thoughts: Do Air Purifiers Help with Dust? Absolutely! Air purifiers are an essential part of maintaining a dust-free home. They capture airborne dust particles before they can settle or be inhaled, significantly improving your indoor air quality. Equipped with a HEPA filter and used in conjunction with regular cleaning and proper ventilation, air purifiers—like Jaspr—are a powerful tool in the fight against dust.
Read moreHow Cooking Affects Your Indoor Air Quality (and How Jaspr Can Help)
Cooking at home can be an incredibly satisfying experience, filling your space with delicious aromas and the warmth of a freshly prepared meal. But what you may not realize is that cooking can have a big impact on your indoor air quality, even beyond lingering smells. Here’s what you need to know about the effects of cooking on the air in your home—and how a Jaspr air purifier can help keep your indoor air as fresh and clean as possible. View this post on Instagram A post shared by Jaspr® ⛰️ (@jasprco) The Hidden Air Pollutants Lurking in Your Kitchen Every time you cook, tiny particles and gases are released into the air, even if you can’t always see or smell them. Some of these pollutants include: • Particulate matter (PM): When cooking with oil, high heat, or open flames, tiny particles are released into the air. These particles can irritate the respiratory system and worsen allergies. • Volatile Organic Compounds (VOCs): VOCs are gases released from ingredients, oils, and certain cooking methods, especially when using gas stoves. Prolonged exposure to VOCs can cause headaches, dizziness, and respiratory irritation. • Nitrogen Dioxide (NO2): Gas stoves emit nitrogen dioxide, which, when combined with other indoor pollutants, can lead to respiratory issues, particularly for those with asthma or sensitive lungs. • Smoke and Odors: Even the most delicious dishes leave behind smoke and odors that can linger long after you’ve finished cooking, affecting the freshness of your air and your home’s overall environment. Quick Fact: Studies have shown that cooking with gas can emit pollutants at levels higher than what the EPA deems safe for outdoor air quality. That means indoor air during cooking can sometimes be worse than the air outside! View this post on Instagram A post shared by Jaspr® ⛰️ (@jasprco) How Poor Kitchen Air Quality Can Impact Your Health Air pollution from cooking doesn’t just linger in the kitchen. Without proper ventilation, these pollutants can spread to other areas of your home, impacting the air you breathe daily. Some of the health effects include: 1. Respiratory Issues: Particulate matter, nitrogen dioxide, and VOCs can irritate the respiratory system, causing symptoms like coughing, wheezing, and even asthma flare-ups. 2. Headaches and Fatigue: Exposure to VOCs and nitrogen dioxide can lead to headaches, dizziness, and even chronic fatigue over time. 3. Allergies and Irritation: If you’re prone to allergies, pollutants from cooking can make symptoms worse, leading to itchy eyes, congestion, and sore throats. 4. Decreased Sleep Quality: The quality of air in your home affects your sleep. Lingering pollutants from cooking can disturb restful breathing patterns and negatively impact sleep quality. The Limitations of Kitchen Ventilation Systems View this post on Instagram A post shared by Jaspr® ⛰️ (@jasprco) Most kitchens come equipped with range hoods or exhaust fans, but these systems alone aren’t always enough to handle the pollutants created by cooking. Here’s why: • Limited Effectiveness: Many kitchen hoods only capture a portion of the pollutants, especially when not used at full power or when they aren’t directly above the cooking area. • Noise: Some fans are noisy, so people might avoid using them at high settings. • Circulation Issues: Hoods and vents don’t typically capture pollutants that spread beyond the immediate cooking space, meaning that particles and odors can still linger in other parts of the home. Why You Need Jaspr to Keep Your Air Clean While Cooking The Jaspr air purifier is uniquely designed to tackle these indoor air quality challenges, giving you an extra layer of protection that goes beyond the kitchen. 1. Advanced Filtration System for Kitchen-Specific Pollutants Jaspr’s filtration technology captures even the smallest particulate matter, VOCs, and nitrogen dioxide, providing a comprehensive solution to kitchen pollution. With Jaspr, you can be confident that your air is consistently filtered of the most common cooking pollutants. 2. Odor Elimination for a Fresher Home Environment Cooking smells can be stubborn, but Jaspr’s powerful filtration system is designed to neutralize odors, so you’re not left with the remnants of last night’s dinner lingering in the air. Say goodbye to residual cooking smells that can dampen the freshness of your home. 3. Protection Against Long-Term Exposure Regular exposure to cooking pollutants, especially in poorly ventilated spaces, can have lasting effects on health. The Jaspr air purifier is equipped to provide continuous, powerful air cleaning, meaning you’re protected from prolonged exposure to irritants and pollutants that can build up over time. 4. Silent Operation for Continuous Use Unlike noisy exhaust fans, the Jaspr air purifier operates quietly, making it easy to leave running while you cook and even overnight to ensure any lingering pollutants are captured. This means you don’t have to choose between clean air and peace and quiet. 5. Whole-Home Air Quality Improvement While kitchen hoods are limited to the cooking area, the Jaspr air purifier works to improve air quality throughout your home. Its advanced filtration reaches other rooms, ensuring that pollutants don’t travel beyond the kitchen, so you and your family can breathe cleaner air in every room. How to Use Jaspr for the Best Kitchen Air Quality Here are a few tips to get the most out of your Jaspr air purifier when cooking: • Position Near the Kitchen: For best results, place your Jaspr air purifier near the cooking area. It can help to capture pollutants as they’re released, preventing them from spreading. • Run Continuously During Cooking: Let the air purifier run continuously while you’re cooking and for at least 30 minutes afterward. This allows it to capture airborne particles and lingering odors. • Use Alongside Your Range Hood: While your range hood handles immediate fumes and smoke, Jaspr will help capture what the hood can’t reach, especially if cooking odors and particles move to other parts of your home. Breathe Easy with Jaspr: Clean Air, No Compromises Cooking shouldn’t have to come with a trade-off in air quality. The Jaspr air purifier offers a simple, effective way to ensure your kitchen and home stay fresh, safe, and healthy. By investing in a Jaspr, you’re not just enhancing your cooking environment—you’re taking steps to protect your family’s health from the hidden effects of indoor air pollution. Ready to transform your indoor air? Visit www.jaspr.co to learn more about how Jaspr can be the perfect addition to your home, helping you cook, breathe, and live better.
Read moreWhat Does a Dehumidifier Do? Improve Your Home’s Air Quality and Comfort
What Does a Dehumidifier Do? A Complete Guide Have you ever walked into a room and felt sticky, heavy air clinging to your skin? That’s the result of excess humidity. A dehumidifier offers a solution by pulling in the humid air, extracting the moisture, and releasing dry, fresh air back into your space. While this process is essential for managing humidity, it’s important to understand how it fits into the broader picture of maintaining a healthy, breathable indoor environment. In this guide, we’ll cover: • How a dehumidifier works • How to use it effectively • Common sources of humidity in your home • The risks associated with high humidity • Why combining a dehumidifier with a high-quality air purifier, like Jaspr, offers the most complete solution How Does a Dehumidifier Work? Dehumidifiers operate by reducing the moisture content in the air. Here’s how it works: 1. Drawing in Humid Air Using a fan, the dehumidifier pulls in humid air but focuses specifically on reducing the moisture content, not filtering out particles like dust or allergens. 2. Condensation Process As the air moves through the dehumidifier’s cooling coils, the moisture condenses into water droplets. These droplets are collected in a reservoir or automatically drained in some models. 3. Releasing Dry Air The now drier air is slightly warmed and released back into the room, making your space more comfortable. 4. Managing Moisture Levels By continuously pulling in moist air and releasing dry air, a dehumidifier can lower the humidity in your space to an ideal range of 45-55%. While dehumidifiers are effective in tackling humidity, they don’t address other air quality issues like allergens, dust, mold spores, and pollen, which is where an air purifier comes in. How to Use a Dehumidifier Effectively To get the most out of your dehumidifier, follow these guidelines: 1. Choose the Right Size Select a dehumidifier that matches the size of your space. Smaller units are suitable for bathrooms, while larger rooms or basements need higher-capacity units. 2. Position it Correctly Place your dehumidifier in the most humid areas, such as near damp walls or in basements, but ensure it’s not obstructed by furniture or walls for proper airflow. 3. Monitor Humidity Levels Aim to maintain a humidity level between 45-55%. Many modern dehumidifiers have built-in hygrometers to help you track and adjust the humidity accordingly. 4. Empty the Water Reservoir If your unit doesn’t have automatic drainage, empty the water tank regularly to prevent overflow. 5. Clean the Filters Clean or replace filters regularly to ensure your dehumidifier operates at peak efficiency. 6. Use in Moderation Avoid overusing a dehumidifier. Excessively dry air can cause health issues like dry skin, irritated sinuses, and respiratory discomfort. The Risks of Excess Humidity High humidity in your home can lead to several problems, including: • Mold Growth Mold thrives in humid environments and can grow on carpets, walls, and even in your air ducts, posing serious health risks. • Dust Mites These microscopic creatures love damp environments and can exacerbate asthma and allergies. • Respiratory Issues High moisture in the air can irritate airways and worsen respiratory conditions, especially for those with asthma or allergies. • Damage to Interiors Excess humidity can warp wood, peel wallpaper, and damage furniture and floors. • Musty Smells Damp environments often produce musty odors. While a dehumidifier helps, pairing it with an air purifier like Jaspr, equipped with activated carbon filters, can eliminate odors and purify the air. The Importance of Combining a Dehumidifier with an Air Purifier While dehumidifiers are excellent at controlling moisture, they don’t address other pollutants like dust, mold spores, or allergens. This is where a high-quality air purifier, like Jaspr, comes into play. An air purifier complements a dehumidifier by filtering out harmful particles that linger in the air. Whether you’re dealing with allergens, mold spores, pollen, or even toxic chemicals that can hitch a ride on dust, Jaspr’s advanced filtration system ensures that your indoor air remains clean and breathable. For many situations, such as preventing mold growth, improving respiratory health, or eliminating odors, an air purifier can actually be a more practical solution than a dehumidifier alone. A Jaspr air purifier doesn’t just manage moisture—it actively cleans the air, creating a healthier environment for you and your family. Final Thoughts Balancing humidity in your home is essential for a healthy and comfortable living environment. While a dehumidifier helps control moisture and prevents problems like mold growth and musty odors, it’s only part of the equation. To fully improve your indoor air quality, pairing a dehumidifier with a high-quality air purifier, like Jaspr, is the best solution. Jaspr air purifiers go beyond moisture control, removing harmful pollutants such as mold spores, dust, allergens, and toxic particles that a dehumidifier can’t address. With Jaspr, you get cleaner, fresher air while maintaining optimal humidity levels. It’s the winning combination for a healthier home. FAQs What humidity level should I set for my dehumidifier? You should aim to keep indoor humidity between 45% and 55%. This range helps prevent mold growth and reduces allergens without making the air too dry. Can using a dehumidifier cause dry air problems? Yes, overusing a dehumidifier can cause the air to become too dry, leading to issues such as dry skin, irritated sinuses, and throat discomfort. That’s why it’s important to monitor humidity levels. Should I use a dehumidifier and air purifier together? Absolutely. While a dehumidifier controls moisture, it doesn’t filter out pollutants like mold spores, dust, or allergens. An air purifier, especially a high-quality one like Jaspr, actively removes these harmful particles from the air. In many cases, an air purifier is actually the more practical solution, providing a comprehensive approach to cleaner, healthier air. Is an air purifier like Jaspr a better option than a dehumidifier? For many air quality concerns, yes. A commercial-grade air purifier like Jaspr not only removes moisture-related pollutants like mold spores but also tackles dust, pollen, and allergens, which a dehumidifier cannot address. It’s often a more effective and versatile solution for improving overall indoor air quality.
Read moreHouse Smells Musty But No Mold? Causes and Solutions Explained
House Smells Musty But No Mold? Causes and Fixes If your house has a constant musty smell, but there’s no visible mold, it can be frustrating. This persistent odor may be the result of hidden mold infestations, or it could stem from other factors like high humidity, poor ventilation, or undetected water damage. Even without visible mold, moisture and stale air can create that musty scent. Addressing these issues with a dehumidifier and improving ventilation can help, but the most effective way to tackle musty odors is by using an air purifier with activated carbon filters, like Jaspr. This not only eliminates musty smells but also removes airborne mold spores, ensuring your home’s air is fresh and healthy. Why Does Your House Have Musty Odors? Musty odors are typically caused by excess moisture and poor air circulation, which create an environment where odor-causing bacteria, mold, and other microorganisms can thrive. Even if there’s no visible mold, these conditions can still create a musty scent. Here are some common reasons why your house might smell musty: High Humidity Levels When the air in your home is excessively humid, it can lead to condensation on surfaces like walls, floors, and ceilings. Moisture seeping into porous materials encourages the growth of microorganisms that produce musty smells. Poor Ventilation Homes with inadequate ventilation trap stale air and moisture, especially in confined spaces like basements, attics, and bathrooms. Without proper airflow, these areas become prime locations for musty odors to develop as moisture lingers. Unmaintained HVAC Systems If your heating, ventilation, and air conditioning (HVAC) systems are not regularly cleaned, they can circulate musty air throughout your home. Dust, debris, and moisture trapped in air ducts can contribute to stale, musty smells, especially when the system is running. Hidden Water Damage and Mold Even if you don’t see any visible mold, hidden water damage from leaks can create a musty odor. Water seeping into walls, floors, or insulation creates damp conditions that encourage the growth of mold and mildew, often leading to musty smells. Where Does Hidden Mold Most Often Occur? If you’re concerned the musty smell could be due to mold, here are some common places to check for hidden mold: • Under Sinks: Leaks from plumbing fixtures, especially under sinks, can accumulate moisture, creating a breeding ground for mold. • Behind Drywall: Water from leaks in plumbing or exterior walls can seep into the wall cavity, allowing mold to grow out of sight. • Around Washing Machines: Moisture around front-loading washing machines, especially near the door seal or underneath the machine, can lead to hidden mold growth. How To Eliminate Musty Smells From Your House Getting rid of a musty smell requires identifying and eliminating the source of the odor. While you might be tempted to mask the smell with scented candles or diffusers, these products can add harmful chemicals to the air. Instead, take these practical steps to freshen up your living space: 1. Use Air Purifiers The most effective and healthy way to eliminate musty odors is by using an air purifier with activated carbon filters, such as Jaspr. Activated carbon filters are specifically designed to trap and neutralize odors, including musty smells, by absorbing airborne particles and volatile organic compounds (VOCs). Jaspr goes beyond just removing odors. It also captures mold spores that could be floating in the air due to hidden mold infestations. With its sleek design, Jaspr blends seamlessly into your home, while ensuring cleaner, healthier air, reducing the risk of respiratory issues. 2. Reduce Humidity Levels Use a dehumidifier in areas with high moisture levels, such as basements, bathrooms, and kitchens. Reducing excess moisture helps prevent the conditions that lead to musty smells. Improving air circulation by opening windows and doors is another simple way to combat humidity. 3. Improve Ventilation Regularly opening windows allows fresh air to circulate through your home, helping to flush out stale, musty air. Use fans to move air around the house, especially in areas where ventilation is poor, like basements and bathrooms. Final Thoughts A musty odor in your home can be more than just a nuisance—it could be a sign of hidden moisture or mold issues. The best approach to eliminating these odors is a combination of reducing moisture, improving ventilation, and using a high-quality air purifier like Jaspr. By taking these steps, you’ll not only eliminate musty smells but also improve your indoor air quality, making your home healthier for you and your family. FAQs Can an air purifier really eliminate musty smells? Yes! An air purifier like Jaspr equipped with activated carbon filters is designed to trap and neutralize musty odors by absorbing airborne particles and VOCs. Additionally, it helps capture mold spores that may be causing the smell. Do I need a dehumidifier as well? Yes, a dehumidifier is important for controlling excess moisture, which is often the root cause of musty smells. By reducing humidity, you create an environment less conducive to mold and odor development. What’s the difference between using an air purifier and improving ventilation? While ventilation helps by moving stale air out and bringing fresh air in, an air purifier actively cleans the air, removing odor-causing particles, mold spores, and VOCs. For comprehensive odor removal, combining ventilation with an air purifier like Jaspr is the most effective approach. Why is my house musty if I don’t see any mold? Even if you don’t see visible mold, musty odors can still result from hidden water damage, poor ventilation, or excess humidity. Mold spores and other microorganisms can thrive in these conditions, creating the musty smell.
Read more
Activated Carbon Filters: Working, Benefits, & Limitations
Learn about activated carbon and it's impact on air purification.
Read more




